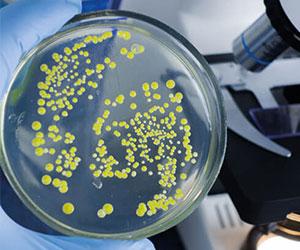

Dossiers
Plaies traumatiques et soins chez le sujet âgé (1/6)
Article publiée dans santé log Soins à domicile n°NL SAD 107 le 31-03-2026
Favorisée par de multiples facteurs dont le vieillissement des populations, l’incidence des traumatismes du sujet âgé est en pleine croissance. Leur impact est à la fois individuel et collectif. Les conséquences osseuses ou fractures constituent un type de lésions connues de tous mais les lésions majeures des parties molles, moins connues, ont un impact tout aussi important.
La morbimortalité de ces traumatismes est conséquente avec un taux d’hospitalisation prolongé, de complications cutanées, de séquelles et de décès significatifs.
Une prise en charge pluridisciplinaire adaptée est nécessaire, notamment au domicile afin d’optimiser la gestion conservatrice de ces patients âgés.
L’objectif principal est de regagner au plus vite une autonomie avec des séquelles fonctionnelles limitées.
Le soignant se doit d’être informé formé à l’évaluation, aux traitements de de ces principales lésions traumatiques afin de pouvoir mettre en œuvre à l’hôpital, comme au domicile, une prise en charge et des soins adaptés à chaque étape.
C.C.
Auteurs
Rédaction : Choufani Camille, Chirurgien orthopédiste, HIA Ste Anne, Toulon
Les autres dossiers
Ulcérations : Des soins de plaie complexes (1/8)
Article publiée dans santé log Soins à domicile n°NL SAD 106 le 29/01/2026
Cicatrisation dirigée (1/3)
Article publiée dans santé log Soins à domicile n°NL SAD 105 le 27/11/2025
Prise en charge des lymphoedèmes (1/6)
Article publiée dans santé log Soins à domicile n°NL SAD 104 le 30/09/2025
Soin de l’escarre, une plaie de santé publique (1/9)
Article publiée dans santé log Soins à domicile n°NL SAD 103 le 27/05/2025
Nécrose, fibrose deux défis de la cicatrisation (1/4)
Article publiée dans santé log Soins à domicile n°NL SAD 102 le 27/03/2025
Soin des stomies et des plaies des tissus mous (1/5)
Article publiée dans santé log Soins à domicile n°NL 101 le 25/01/2025
Créer votre compte gratuitement
Et accédez sans limite à
plus de 600 dossiers
Les archives
-
Zoom sur les plaies chroniques (1/3)
-
Soins de plaies - Les nouveautés 2023 en Plaies et Cicatrisation (1/9)
-
Prise en charge de la stomie, une plaie des tissus mous (1/6)
-
Toxicités, plaies cutanées et prise en charge de la douleur en oncologie (1/12)
-
Hygiène, désinfection, IAS et Soin de la plaie infectée (1/10)
-
Escarre : Mobilisation, évaluation, cicatrisation (1/8)
Pages